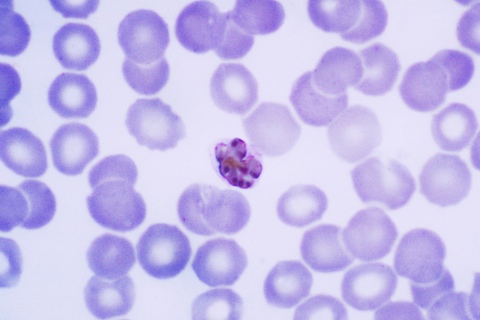
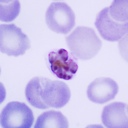
External Image

About: Plasmodium malariae Feletti and Grassi 1889 Goto Sponge NotDistinct Permalink
An Entity of Type : http://lod.taxonconcept.org/ontology/txn.owl#SpeciesConcept,
within Data Space : taxref.i3s.unice.fr associated with source document(s)
| Attributes | Values |
|---|---|
| rdf:type | |
| sameAs | |
| skos:prefLabel |
|
| foaf:depiction | |
| http://www.w3.org/...der-s#describedby | |
| authority |
|
| dct:hasPart | |
| class |
|
| commonName |
|
| family |
|
| genus |
|
| hasWikipediaArticle | |
| hasWikispeciesArticle | |
| kingdom |
|
| order |
|
| phylum |
|
| scientificName |
|
| taxonNameID | |
| thumbnail | |
| uniprotClass | |
| uniprotFamily | |
| dct:isPartOf | |
| is taxonNameID_Of of | |
| is dct:isPartOf of |
Faceted Search & Find service v1.13.91 as of Jun 18 2018


![[RDF Data]](/fct/images/sw-rdf-blue.png)
OpenLink Virtuoso version 07.20.3217 as of Jun 15 2018, on Linux (x86_64-unknown-linux-gnu), Single-Server Edition (31 GB total memory)
Data on this page belongs to its respective rights holders.
Virtuoso Faceted Browser Copyright © 2009-2026 OpenLink Software


![[RDF Data]](/fct/images/sw-rdf-blue.png)
OpenLink Virtuoso version 07.20.3217 as of Jun 15 2018, on Linux (x86_64-unknown-linux-gnu), Single-Server Edition (31 GB total memory)
Data on this page belongs to its respective rights holders.
Virtuoso Faceted Browser Copyright © 2009-2026 OpenLink Software